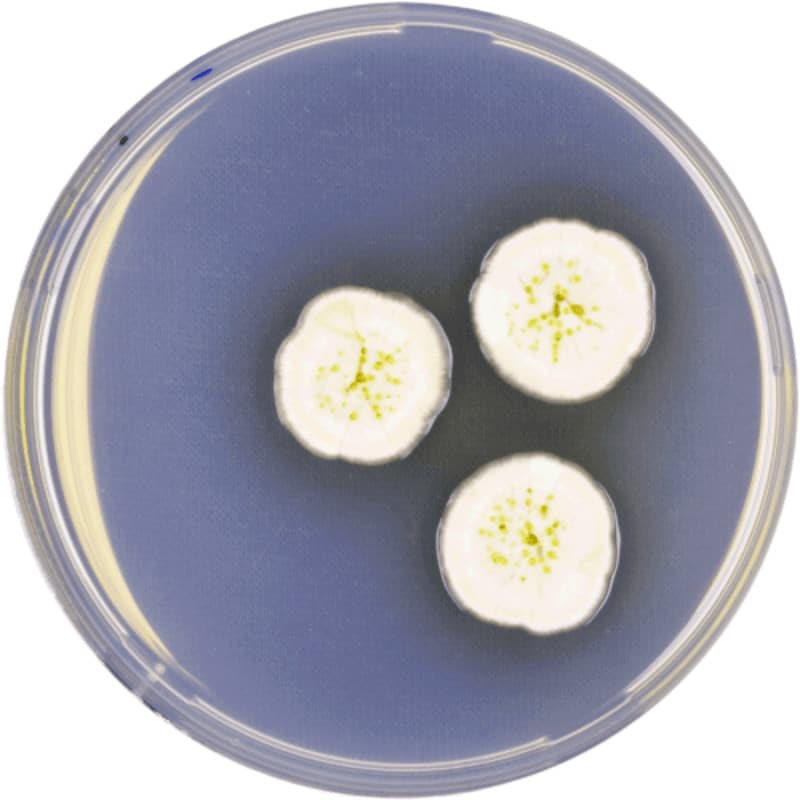
GPL-MycoTox Profile 19 Aspergillus
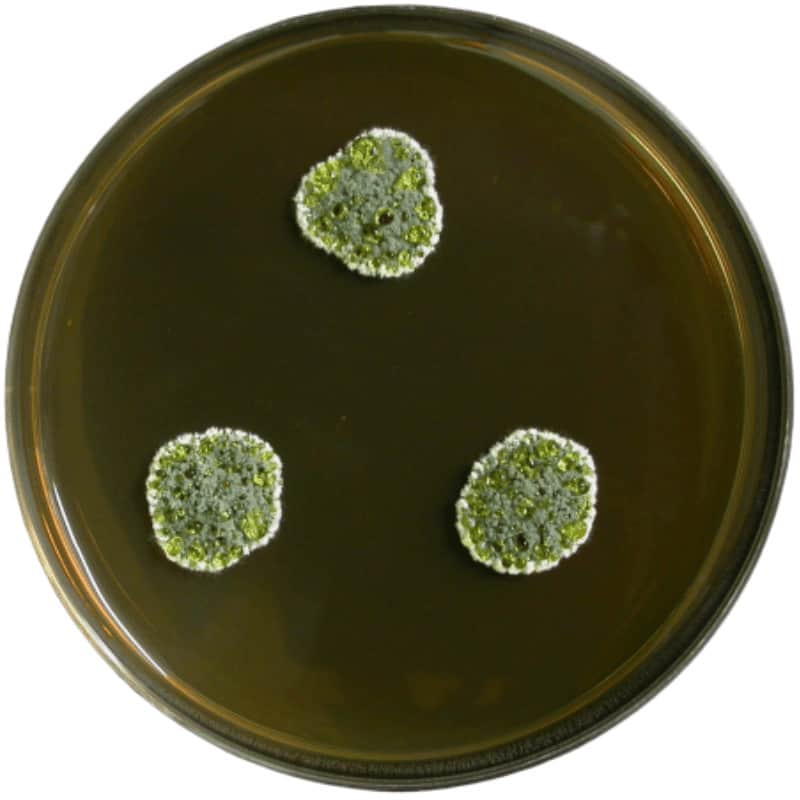
GPL-MycoTox Profile 20 Penicillium
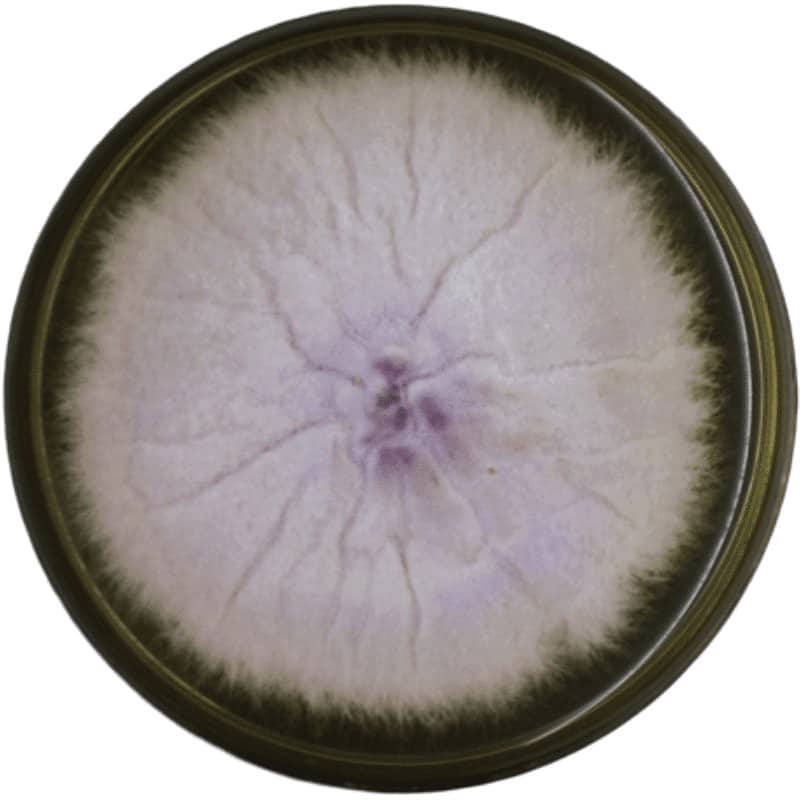
GPL-MycoTox Profile 22 Fusarium

Take Control Of Your Health
With The Comprehensive MycoTOX Profile by Great Plains Laboratory
If your outside the U.S. email tests@planetnaturopath.com for a quote
We cannot ship directly to New York – contact us for other options
The GPL-MycoTox Profile Is For Anyone Experiencing

Respiratory Symptoms

Neurological and Psychiatric Symptoms

Musculoskeletal Symptoms

Skin Symptoms

Gastrointestinal Symptoms

Hormonal Symptoms
Our in-depth MycoTox test analysis can help you discover

Exposure to Aspergillus, Penicillium, Stachybotrys, Fusarium and 11 different mycotoxins, from 40 species of mold ( in one urine sample).

Lower levels of fungal toxins with the help of advanced mass spectrometry (MS/MS), which make MycoTox great for follow up testing.

Whether the reason for your respiratory problems, fatigue and rashes is mold toxicity or some other allergens or disorders.

Exactly what your test results mean through both a detailed PDF report, written summary and a private one-on-one consultation.

How to optimize your health with customized recommendations for diet, nutritional supplements, exercise, and lifestyle modifications based on your test results.
Mosaic labs – MycoTox
Have already done testing but need help with interpretation of results?
If you’ve already done the MycoTox test and just need some guidance to understand the results and help you
with a treatment plan, don’t hesitate to schedule a consultation.
What the GPL-MycoTox Profile Covers and How It Can Benefit You
Mycotoxins are metabolites produced by fungi like mold, which can infest your home and affect your health. The mycotoxin exposure can be the underlying cause of asthma, heart disease, rheumatic disease, chronic fatigue, skin rashes, and mental disorders.
The MycoTox Profile offers a comprehensive analysis of common household mold types and mycotoxin markers using advanced mass spectrometry (MS/MS).
if your outside the U.S email tests@planetnaturopath.com for a quote
Hi, my name is Michael Smith, ND BHSC and Head Practitioner at Planet Naturopath.
I have a passion for health and fitness. I also have a passion for helping guide other people so that they can reach their best possible health, which I have been doing for the last 15 years.
If you’re looking to find out what the underlying cause is behind your digestion issues, hormone problems, fatigue, autoimmune or other health conditions then you have come to the right place.

I also have a special interest in optimizing brain function.
I can help you by analyzing your diet and nutrition, doing detailed functional pathology testing to get to the root cause of your problem, and help guide you on the journey to wellness.
I specialize in Digestion and Hormonal dysfunction which is often the cause of many people’s health complaints, and they may not even realize it. If you optimize these systems it can lead to improved weight, increased energy, improved hair, skin and nails, better moods and many other symptoms disappearing.
I don’t provide a “magic pill” to wellness—you will have to put time and effort in to change your diet and nutrition—but I can help to guide, educate and inspire you to achieve great results.
How to order the MycoTox test
Click “Order Now”
Click Below on the “ Order Now “ button to order your MycoTox Test
Fill out the form with your:
Check your email
You will receive a confirmation email from Planet Naturopath that explains exactly what to do next.
Your MycoTox Test Kit will arrive via priority mail
Your MycoTox Test Kit will arrive via priority mail within 2-4 days depending on your location.
The test kit will include:
You will receive your results and do your consultation
You will receive your results via email within 10-15 days of the lab receiving your sample. In that same email will be a link to schedule your online consultation with Planet Naturopath.
You can do your consultation by phone, or Skype, but we’d like to suggest our convenient video teleconferencing service that we use to do the majority of our consultations. It’s simple to use, free, and doesn’t require you to sign up or download anything.
After you schedule your online consultation, you’ll also fill out our short questionnaire regarding your health history and health concerns.
This allows me to analyze your most accurate and up-to-date health information and combine it with your GI-MAP Test results to give you the most in-depth personalized consultation possible.
During your 45-minute private one-on-one consultation, I’ll explain your results in an easy-to-understand language, and answer any questions you might have.
You’ll also receive diet, exercise and supplement advice, options and recommendations that you can immediately implement to start optimizing your digestion and overall health.
Your official results and customized PDF report with your step by step Optimal Health Plan will be emailed the next day.
Order your MycoTox Test today to receive the most complete and accurate analysis of mycotoxin levels
MycoTox Test Kit, your 45-minute private one-on-one consultation, your customized PDF report with detailed specific recommendations for diet, nutritional supplements, and exercise plan for $449.
Let me analyze your results, give you a breakdown of what your ranges mean – whether they’re elevated, normal, or low. And answer any questions you might have – plus give you options and recommendations on how you can optimize your heart health.
At Planet Naturopath, we want you to feel safe, confident, and secure when you purchase any of our tests, knowing that you’re protected by our:
If you’re not satisfied with the service we provide at Planet Naturopath – let us know within 30 days and you’ll receive a full refund, minus the shipping and handling costs.
Now obviously, we can’t guarantee that your results will be good – that’s kinda the whole reason you’re here right? To see where you’re at and what natural solutions are available to improve your health…
But we will guarantee you’ll get the best service and most professional and personalized advice available to help optimize your health with natural solutions.
We understand how frustrating it can be when you don’t feel right – but yet you’re told by a doctor there’s nothing wrong.
A Planet Naturopath we believe your health is the key to a long and happy life. And want to be there to help when you don’t get the answers you want through conventional medicine.
Yours in good health.
Michael Smith
Head Pract. Planet Naturopath.
P.S. Still not sure if the Mycotoxin Test is the right test for you? Don’t worry, Planet Naturopath has got you covered.
Schedule our Investigation Consultation, a deep dive into your health history, symptoms, and concerns. We’ll help assess your situation and provide you with expert advice and options on your best course of action and which test is right for you.
If you’re unsure of exactly where to begin, this eliminates the guesswork and gives you a great start to better health.
Please Note: Services in the US cannot be shipped to these states NY and RI. Please email support@planetnaturopath.com to discuss alternative solutions and options available.